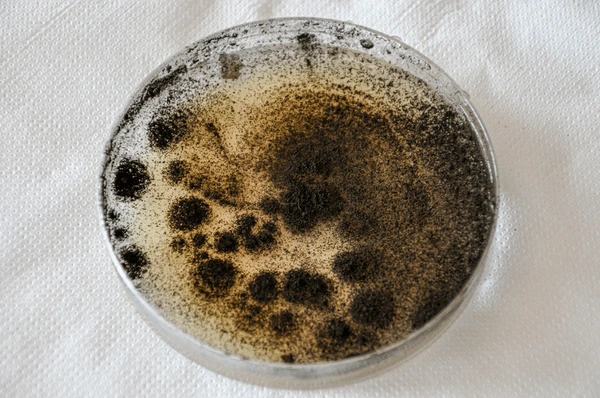
Zuzana Kalaninová

Proč už nepodporujeme prohlížeč Internet Explorer
Prohlížeč Internet Explorer již nepodporujeme a také důrazně nedoporučujeme, protože dlouhodobě funguje bez zásadních aktualizací, vylepšení a podpory. Obsahuje řadu závažných bezpečnostních rizik, které mohou způsobit únik citlivých informací a vašich osobních dat. Nehledě k tomu, že prohlížení a práce s webovými stránkami je v něm pomalejší až o 50 % v porovnání s ostatními prohlížeči.
Které prohlížeče tedy používat a kde si je můžete stáhnout?
Změna prohlížeče je jednoduchá, nezabere vám moc času a my vám s ní pomůžeme. Nachystali jsme pro vás seznam doporučených prohlížečů.
Vyberte si prohlížeč a klikněte na jeho název. Otevře se vám stránka, na které si prohlížeč můžete bezpečně nainstalovat.
TIP: Klidně si můžete nainstalovat všechny a vyzkoušet si, jak se vám s nimi pracuje.
A nebojte se, že změnou přijdete o všechny záložky, historii a uložená hesla. Můžete si je totiž jednoduše přenést. Postup pro dva nejpoužívanější prohlížeče přidáváme.
Doporučené prohlížeče:
Mozilla Firefox je výkonný, stabilní a bezpečný prohlížeč. Záložky a další data si můžete přenést podle návodu zde.
https://www.mozilla.org/cs/firefox/
https://support.mozilla.org/cs/kb/import-zalozek-dalsich-dat-z-internet-exploreru-ne
Google Chrome je rychlý, jednoduchý a bezpečný prohlížeč. Podívejte se na návod, jak přenést záložky a ostatní informace do Google Chrome.
https://www.google.com/intl/cs_ALL/chrome/security/
https://support.google.com/chrome/answer/96816?hl=cs